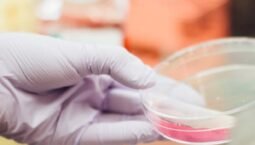
placeholder

Lietuvos podologų asociacija – tai profesionali bendruomenė, veikianti siekiant podologijos profesijos įteisinimo, specialistų kompetencijų stiprinimo ir visuomenės švietimo pėdų sveikatos klausimais.
Kas yra Lietuvos podologų asociacija?
Mūsų tikslas
kelti podologijos profesinį lygį, stiprinti specialistų kompetencijas, atstovauti jų interesams ir skatinti visuomenės sąmoningumą apie pėdų sveikatą.
Vizija
Podologija – pripažinta ir reglamentuota, aiškiai apibrėžta sveikatos priežiūros sritis Lietuvoje, grindžiama medicinos normą,, užtikrinanti aukščiausią paslaugų kokybę ir pacientų saugumą.
Misija
Vienyti podologijos ir pėdų priežiūros specialistus bendram tikslui – podologijos profesijos įteisinimui ir pripažinimui valstybiniu lygiu, formuojant atsakingą ir stiprią profesinę bendruomenę.